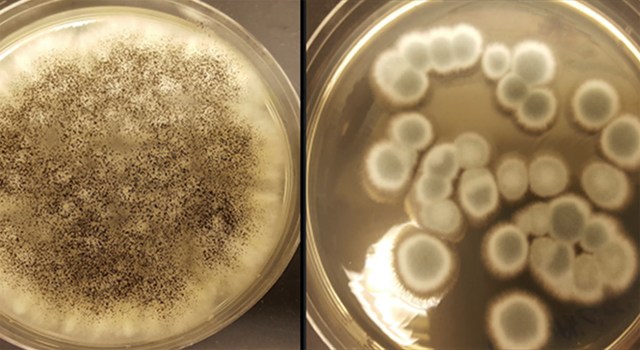
Fungi recycle rechargeable lithium-ion batteries

-
The accident Eghyptians and the chinese , both developed ink approximately the same time around 2500.
-
In 1981,one fality and two hospitalitions ocurred followin consuptions of Galerina autumnails mistaken for a psilocybe species.
-
In 1928 Sir Alexander discover penicilin , a key antibiotic in the treantment of infections ,wich led to fall in death rate.
-
the first synthetic dye was william perkin mawrene in 1856 , derived from coal tar .
-
Philadelphia Aug.21,2016-Although rechalgable,bateries in smartphones,cars and tablets can be charged again and again, they dont last forever.The mushrooms will become batteries to charge our electronic devices.
Want to make a timeline like this?
Use Timetoast to turn dates, events, milestones, and phases into a clear visual timeline you can build and share. Timetoast is a timeline maker for work, school, research, and stories.